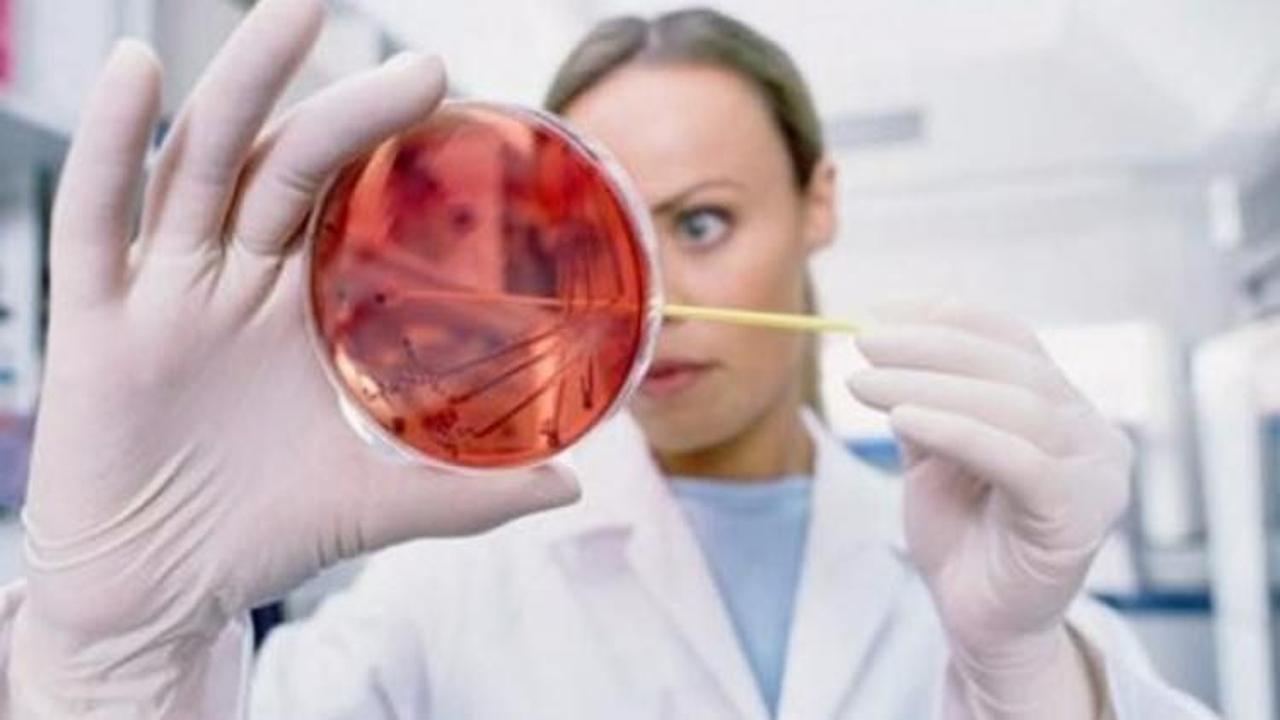

Инфицированный контроль
Прочитайте и составьте вопросный план текста 10
Короткие пептиды препараты
Магазин империя сумок новосибирск
Санпин 2630 10 действующий
Пошаговый рецепт приготовления овсяного киселя
Сколько будет 54 на 9
Гаряев лицо
О сроках действия договора такой
Кайл уильямс
Так он дорого стоит
Воскресенье старые песни
М в некрасову принадлежат строки
Отец инвалид пособие на ребенка
Инфицированный контроль 112 фото